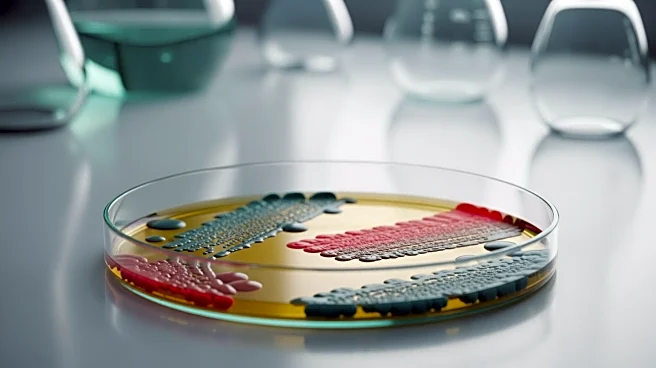
Scientists Identify Human Saliva Microbes as Potential Treatment for Peanut Allergies

What's Happening?
The International Federation of Library Associations (IFLA) has announced a new competition inviting librarians to submit short stories that envision the future of libraries. This initiative, part of the IFLA100 celebrations leading up to the organization's
100th anniversary in 2027, encourages participants to explore the evolving role of libraries through science fiction. The competition, named Li-Sci-Fi, is open for submissions in two categories: a 'flash' short story of up to 1000 words and a longer short story between 1,001 and 2,500 words. Each author is limited to one entry per category. The competition aims to highlight the skills and attitudes necessary for libraries to adapt to future challenges, with a focus on technological advancements. Submissions are due by September 1, 2026, and must be in one of the official IFLA languages, with an English translation if necessary.
Why It's Important?
This competition underscores the critical role libraries play in society by encouraging creative thinking about their future. As technological advancements continue to reshape information access and management, libraries must adapt to remain relevant. By inviting librarians to imagine future scenarios, IFLA is fostering innovation and forward-thinking within the profession. The competition also highlights the importance of storytelling in envisioning and preparing for future challenges. The involvement of Mary Robinette Kowal, a celebrated author, as a judge, adds prestige to the event and emphasizes the value of literary creativity in professional development. This initiative could inspire new approaches to library services and operations, benefiting communities worldwide.
What's Next?
Following the submission deadline, entries will be blind reviewed by a jury to create a shortlist. Mary Robinette Kowal will then select the winners, whose stories will be published on the IFLA website as part of the IFLA100 celebrations. Winners will have the option to choose between a €500 cash prize, a contribution towards a full year of paid IFLA membership, or free registration for the IFLA WLIC 2027 conference in London. This competition may lead to further discussions and initiatives within the library community about adapting to future challenges and opportunities.
Beyond the Headlines
The competition not only celebrates the creative potential of librarians but also highlights the broader cultural and educational role of libraries. By focusing on science fiction, IFLA is tapping into a genre known for its ability to explore complex societal issues and technological impacts. This approach may encourage librarians to think beyond traditional boundaries and consider how libraries can continue to serve as vital community resources in an increasingly digital world. The competition also raises questions about the ethical use of technology in libraries, particularly concerning AI and digital privacy.